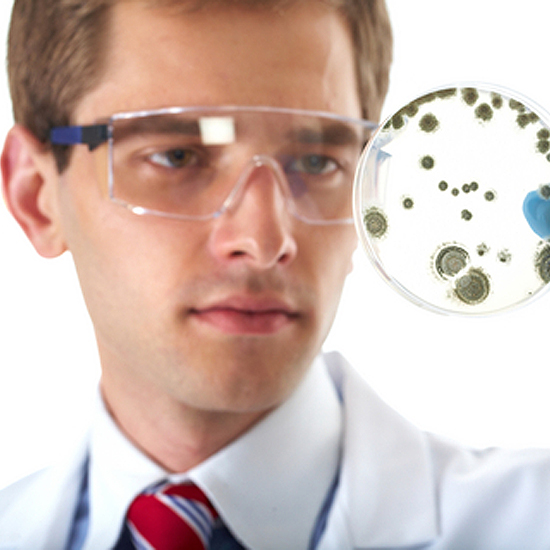

Одні з пріоритетних лікарських спеціальностей для галузі охорони здоров’я — «Епідеміологія» та «Лабораторна діагностика, вірусологія, мікробіологія». Адже наявність достатньої кількості добре навчених лікарів за цими напрямами є одним з ключових чинників забезпечення ефективної профілактики і діагностики захворювань, біологічної безпеки, санітарного та епідемічного добробуту населення.
Одні з пріоритетних лікарських спеціальностей для галузі охорони здоров’я — «Епідеміологія» та «Лабораторна діагностика, вірусологія, мікробіологія». Адже наявність достатньої кількості добре навчених лікарів за цими напрямами є одним з ключових чинників забезпечення ефективної профілактики і діагностики захворювань, біологічної безпеки, санітарного та епідемічного добробуту населення.
Тож протягом 2022–2023 рр. Міністерство охорони здоровʼя України проводило комплекс профорієнтаційних заходів для випускників закладів вищої освіти (далі — ЗВО), в яких здійснюють підготовку в галузі знань 22 «Охорона здоров’я», щодо ознайомлення з перспективами вступу на ці спеціальності.
Переваги вступу на спеціальності
Серед переваг:
- працевлаштування на посаду лікаря-інтерна з відповідним посадовим окладом, а після завершення інтернатури — гарантоване працевлаштування на відповідну лікарську посаду в комунальних закладах охорони здоров’я, центрах контролю і профілактики хвороб МОЗ України, ДУ «Центр громадського здоров’я МОЗ України»;
- можливість продовжити навчання за спеціалізованою програмою підготовки з польової епідеміології та іншими навчальними програмами, в тому числі за кордоном, вступати в аспірантуру, здійснювати безперервний професійний розвиток, здобувати вторинні лікарські спеціалізації медико-профілактичного та медико-лабораторного профілю;
- отримання знань та навичок роботи з даними, статистичного аналізу, проведення досліджень;
- можливість у подальшому працювати на посадах лікарів-епідеміологів, у тому числі таких, які займаються питаннями профілактики інфекцій та інфекційного контролю в закладах охорони здоров’я, а у випадку проходження інтернатури за спеціальністю «Лабораторна діагностика, вірусологія, мікробіологія» — на посадах лікарів-лаборантів, лікарів-вірусологів, лікарів-бактеріологів;
- можливість розвивати кар’єру у сфері громадського здоров’я.
Особливості вступу та проходження інтернатури
Вступити на спеціальність «Епідеміологія» можуть випускники ЗВО ступеня магістра за спеціальностями 222 «Медицина», 228 «Педіатрія».
Тривалість підготовки за цим фахом становить 1 рік. За умови успішної атестації інтерну присвоюється звання «лікар-спеціаліст» за спеціальністю «Епідеміологія».
Вступити на спеціальність «Лабораторна діагностика, вірусологія, мікробіологія» можуть випускники ЗВО ступеня магістра за спеціальностями 222 «Медицина», 224 «Технології медичної діагностики та лікування».
Тривалість підготовки за цим фахом становить 1,5 року. За умови успішної атестації інтерну присвоюється звання «лікар-лаборант» за спеціальністю «Лабораторна діагностика, вірусологія, мікробіологія» (спеціалізації «Клінічна лабораторна діагностика» та «Мікробіологія і вірусологія»).
Зазначимо, що підготовка майбутніх лікарів-епідеміологів та лікарів-лаборантів здійснюється за навчальними програмами, розробленими ЗВО на основі примірних програм підготовки в інтернатурі за спеціальностями «Епідеміологія», «Лабораторна діагностика, вірусологія, мікробіологія».
Особливістю цих програм є те, що вони розроблялися на основі європейських вимог та компетентнісного підходу. Саме це забезпечуватиме якісну підготовку лікарів-інтернів відповідно до сучасних європейських тенденцій розвитку охорони здоров’я.
Долучайтеся до нас у Viber-спільноті, Telegram-каналі, Instagram, на сторінці Facebook, а також Twitter, щоб першими отримувати найсвіжіші та найактуальніші новини зі світу медицини.
Редакція журналу «Український медичний часопис» за матеріалами moz.gov.ua





